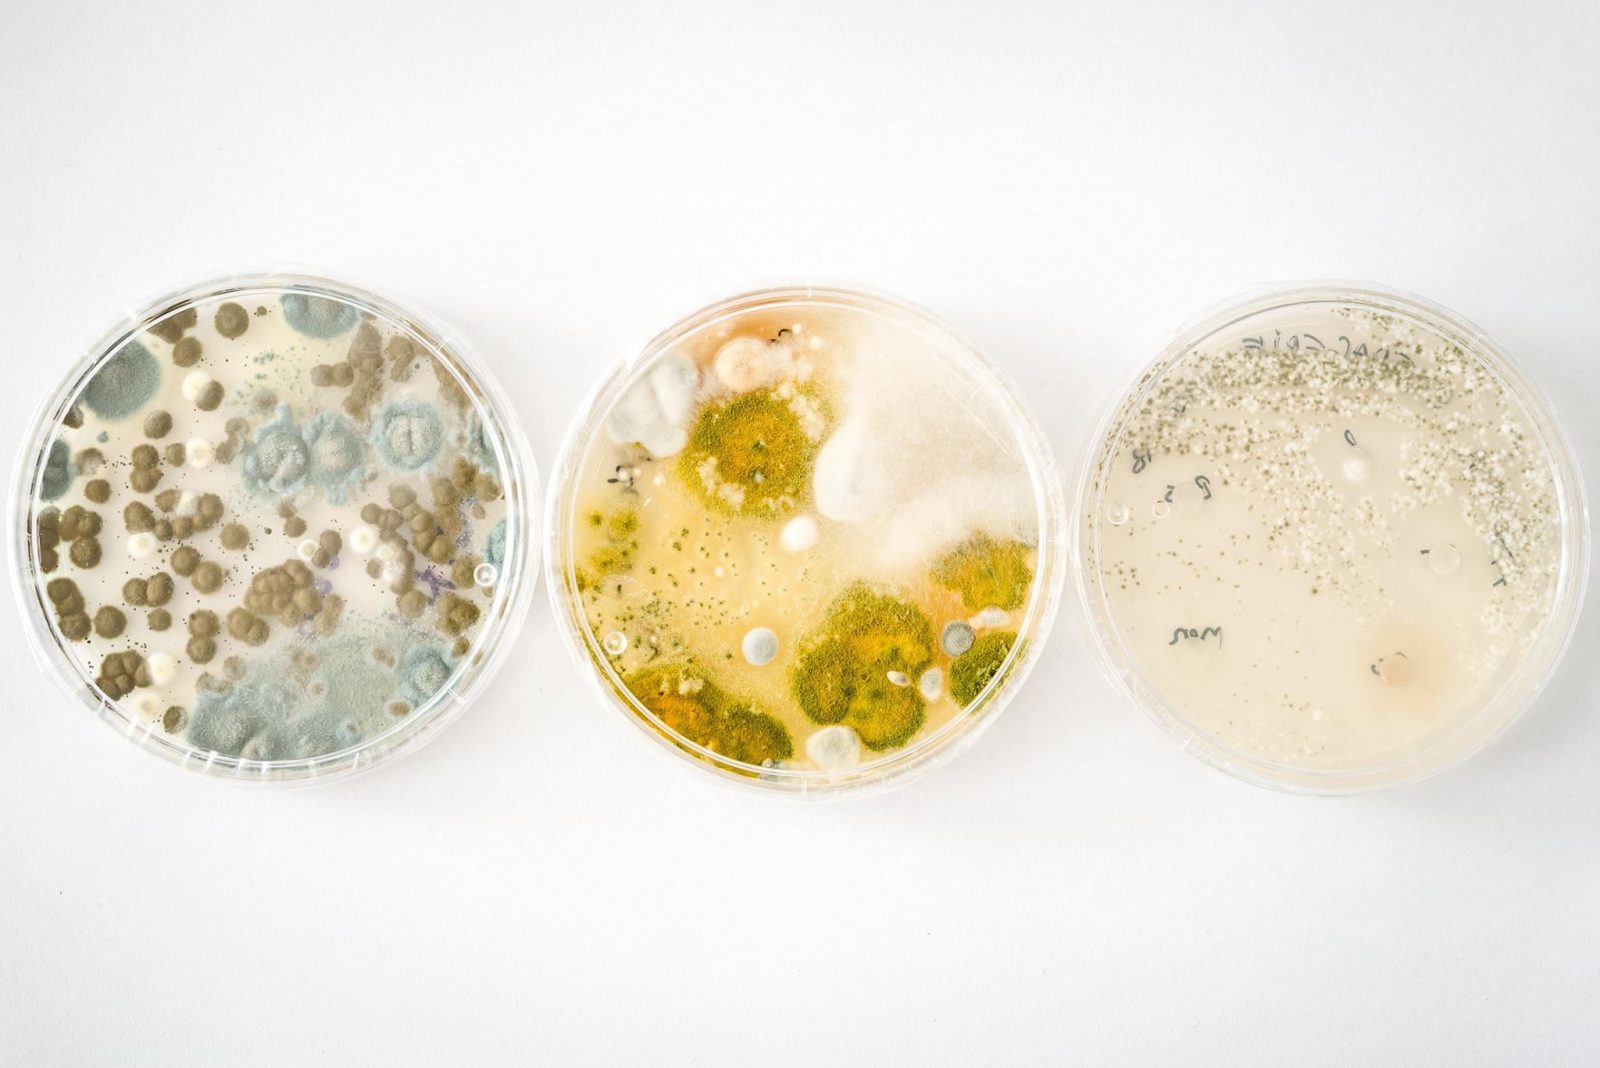

Problemele calităţii aerului din interiorul clădirilor sunt recunoscute ca factori de risc major pentru sănătatea umană. Calitatea aerului din interior reprezintă un aspect important, întrucât oamenii petrec marea majoritate a timpului în interiorul clădirilor.
Mucegaiurile se găsesc peste tot în jurul nostru în mod natural, în special sporii acestora. Însă atunci când numărul lor crește, pot provoca boli, în general afecțiuni respiratorii. Din nefericire, aceasta este o problemă în Sibiu, dar nu numai, din cauza numărului mare de clădiri vechi afectate de mucegaiuri. Problema este prezentă de asemenea și în locuințele construite mai recent.
Scopul proiectului este găsirea unor alternative ecologice și inofensive pentru fungicidele și substanțele folosite în combaterea mucegaiurilor ce se dezvoltă în preajma oamenilor.
Mai multe poze găsiți aici. Foto: Gabriela Cuzepan
Echipa:
- Avram Carina-Andreea – coordonator activitate, profesor de biologie
- Dumitru Vasile Cosmin – coordonator activitate, biolog
- Stănilă Elena Denisa – coordonator activitate, antreprenor, biolog
- Prof. Banea Ioan Marius – voluntar, profesor
- Malacu Călin Marian – voluntar
Beneficiari: 7 liceeni între 14-17 ani
Finanțare: 5.918 lei
Activități: Aprilie 2018